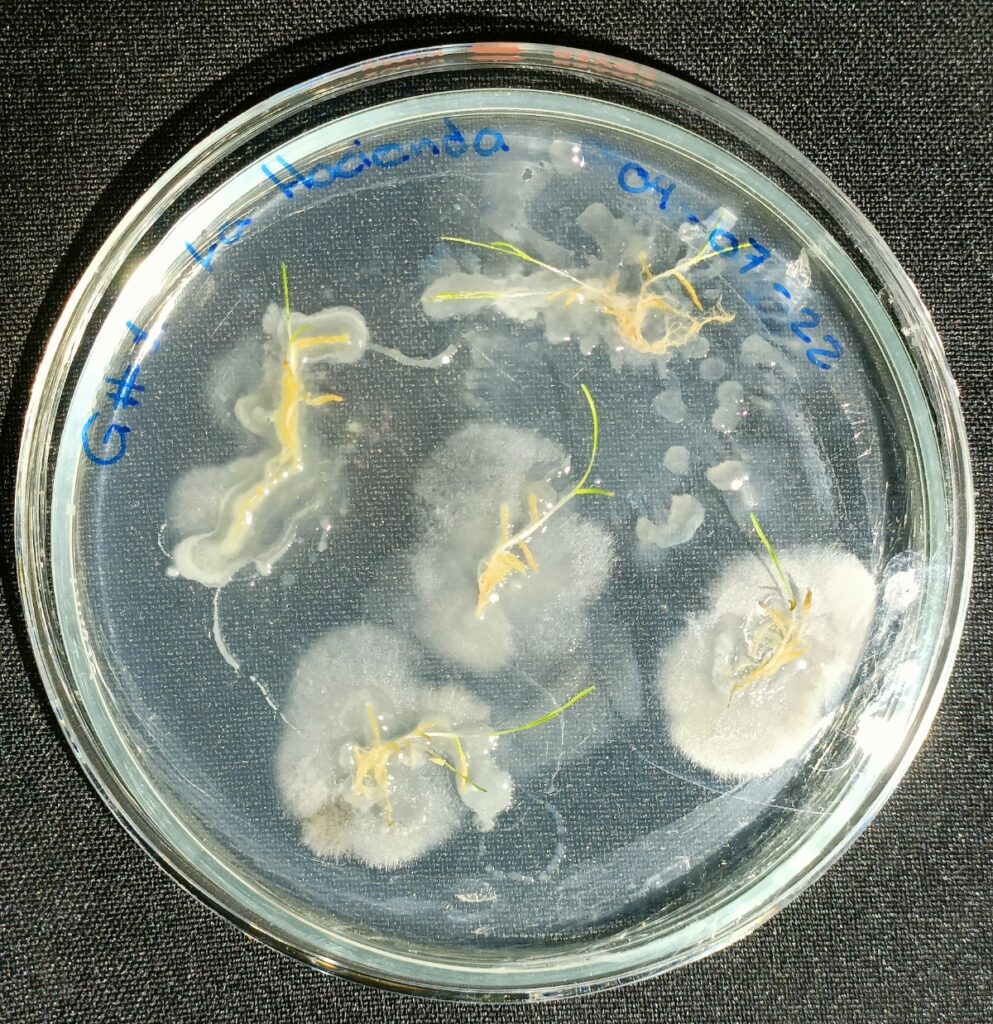

Diagnóstico de Bacterias en Semilla, Suelo, Arena, Sustrato, Raíces, Césped y Agua
Las bacterias fitopatógenas representan un riesgo importante para la calidad y funcionalidad de superficies verdes, especialmente en campos de golf, áreas verdes y canchas deportivas, donde los estándares estéticos y de jugabilidad son elevados. Su presencia puede provocar pérdida de densidad del césped, manchas irregulares, debilitamiento radicular y deterioro general del área afectada.
En Solmanag, ofrecemos un servicio especializado de diagnóstico de bacterias en diferentes matrices, incluyendo semilla, suelo, arena, sustrato, raíces, césped y agua, con el objetivo de identificar oportunamente el agente causal y apoyar la toma de decisiones técnicas para su manejo adecuado.
Nuestro diagnóstico se basa en el análisis e interpretación técnica de muestras, permitiendo establecer estrategias de manejo más eficientes, precisas y sustentables.
¿Qué incluye el servicio?
Toma y recepción de muestras de:
Semilla
Suelo y arena
Sustratos
Raíces y tejido vegetal
Césped
Agua de riego
Identificación de bacterias asociadas a problemas fitosanitarios
Interpretación técnica de resultados
Recomendaciones generales para el manejo del problema detectado

Beneficios del diagnóstico bacteriano
Identificación precisa del problema antes de aplicar cualquier tratamiento
Prevención de daños severos en césped y superficies de juego
Optimización del uso de insumos fitosanitarios
Reducción de costos por aplicaciones innecesarias
Mejora en la calidad, uniformidad y desempeño del césped
Apoyo técnico para decisiones de manejo más seguras y sustentables
Aplicación del servicio
Este servicio está diseñado exclusivamente para su aplicación en campos de golf, áreas verdes, canchas deportivas y jardinería profesional, considerando las condiciones específicas del césped, suelo, sustratos y sistemas de riego propios de estos espacios.
¿Detectas problemas recurrentes en el césped o superficies verdes de tu campo?
Solicita un diagnóstico bacteriano especializado y recibe respaldo técnico para el manejo adecuado de tu área verde.
